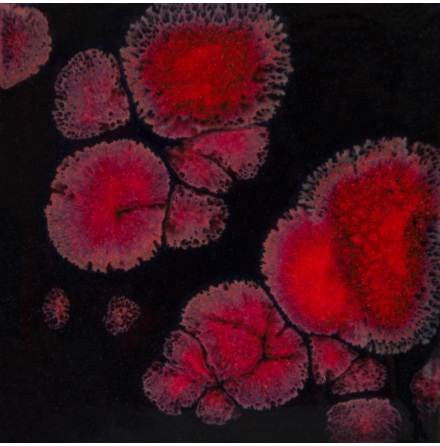
Black Opal

Landväljare
Svenska
SEK
Sök

Lergodsglasyrer för pensling
Våra lergodsglasyrer är färdigblandade, appliceras med en mjuk pensel i 2-4 lager och finns i 118 ml, 276 ml och 473 ml förpackningar. Vi rekommenderar att alltid testa våra glasyrer innan applikation på produktionen, eftersom olika leror, applikationens tjocklek, brännkurvor och temperaturer kan ge olika resultat än visad på vår hemsida.
De flesta av våra glasyrer är livsmedelssäkra. De som inte är det har ett varningstecken på burken och i beskrivningen av glasyren på vår hemsida.
-
från 151 SEK
-
Ej i lagerArtnr. CG-973319 SEK
-
I lagerArtnr. LG-65384 SEK
-
I lagerArtnr. F-65236 SEK
-
Ej i lagerArtnr. EL-107244 SEK
-
I lagerArtnr. LT-34211 SEK
-
Ej i lagerArtnr. NTG-9337190 SEK
-
I lagerArtnr. FN-014241 SEK
-
från 60 SEK
-
I lagerArtnr. O-21280 SEK
-
från 60 SEK
-
I lagerArtnr. EL-133244 SEK
-
I lagerArtnr. O-30280 SEK
-
I lagerArtnr. EM-1273249 SEK
-
I lagerArtnr. A-22231 SEK
-
I lagerArtnr. NTG-9323374 SEK
-
Ej i lagerArtnr. SC80151 SEK
-
Ej i lagerArtnr. CG-1004319 SEK
-
Ej i lagerArtnr. S-2703319 SEK
-
I lagerArtnr. FN-034241 SEK
-
från 241 SEK
-
I lagerArtnr. SBG-4018270 SEK
-
I lagerArtnr. EL-137244 SEK
-
Ej i lagerArtnr. EL-120244 SEK
-
I lagerArtnr. CG-798319 SEK
-
I lagerArtnr. LG-2280 SEK
-
I lagerArtnr. CG-779319 SEK
-
Ej i lagerArtnr. SC-2609249 SEK
-
I lagerArtnr. O-2280 SEK
-
I lagerArtnr. FN-304241 SEK
-
Ej i lagerArtnr. LG-10280 SEK
-
I lagerArtnr. O-10280 SEK
-
I lagerArtnr. CG-974319 SEK
-
Ej i lagerArtnr. FN-006241 SEK
-
I lagerArtnr. CG-962319 SEK
-
I lagerArtnr. CG-718319 SEK